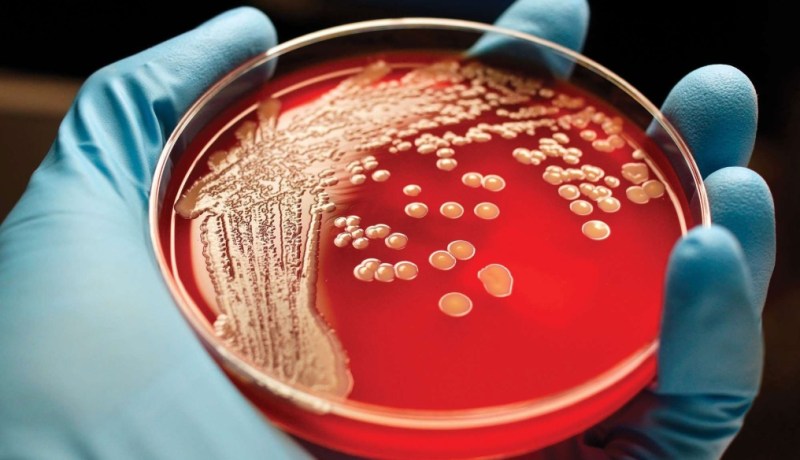
إبتكار لقاح للعلاج والوقاية من أخطر أنواع السرطان

إبتكار لقاح للعلاج والوقاية من أخطر أنواع السرطان
يعتبر العلاج الكيميائي الأكثر فعالية في شفاء المرضى المصابين بسرطان الدم النخاعي الحاد، ولكن خطر الإنتكاس يبقى واردًا دائمًا.
وقالت مجلة “Nature Biomedical Engineering”، بأنّ الحديث يدور حول الأورام الخبيثة التي تتكاثر فيها كريات الدم البيضاء “المصابة” بسرعة، وتكبح تطور خلايا الدم السليمة، حيث أن المصاب بهذا المرض لا يمكن أن يعيش أكثر من 5 سنوات.
وقرر باحثون من مركز بحوث بجامعة هارفارد، إطلاق مجموعة تجارب لإيجاد طريقة لإطالة عمر المصابين بهذا المرض.
وقد تكللت جهودهم بإبتكار لقاح جديد، كانت نتائج إختباره جيدة وإيجابية مع العلاج الكيميائي، حيث تقضي هذه الطريقة على الخلايا السرطانية وتمنع ظهورها ثانية.
ويقول المبتكرون، إنّ اللقاح الجديد كسابقيه يقوم بتدريب منظومة المناعة على إكتشاف الخلايا السرطانية وتحفزها لمكافحتها حال ظهورها.
ولكن هناك إختلاف جذري وحيد يميّز هذا اللقاح، هو أنّه لقاح صلب بخلاف اللقاحات السابقة السائلة، ما يسمح له بالقضاء على “العدو السائل”.
ويتكون اللقاح الجديد من مواد حيوية تحتوي على جزيئات حيوية وأجسام مضادة لخلايا سرطان الدم النخاعي الحاد، مثبتة في بنية قرصية من “كريوجيل” “cryogel”، ما يسمح بتحفيز الإستجابة المناعية حال ظهور خلايا المرض في الجسم.
وقد إختبر الباحثون ابتكارهم على الفئران السليمة أولا لمعرفة هل سيحفز الإستجابة المناعية من خلال تحفيز الخلايا المناعية “T”.
ومن ثم حقنوا الفئران بخلايا سرطانية، وتبين أن جميع الفئران التي حقنت باللقاح الجديد بقيت على قيد الحياة، في حين نفقت الفئران غير الملقحة بعد شهرين.
وبعد مضي 100 يوم حقنت نفس الفئران بخلايا سرطانية للمرة الثانية، ولم يكتشف الباحثون إصابتها بالمرض.
وقد سعى الباحثون إلى تحديد بداية ظهور مرض سرطان الدم النخاعي.
ومن أجل ذلك درسوا بصورة مفصلة تأثير اللقاح في نخاع العظم حيث يولد المرض.
وإتضح لهم وجود الخلايا المناعية “T”، بكثرة في نخاع عظم الفئران الملقحة باللقاح الجديد، ولكنهم لم يجدوا أي أثر للخلايا السرطانية.
ويقول الباحث نزراك شاه، مستقبلًا على أساس هذه النتائج سنتمكن من إنتاج لقاحات شخصية للبشر.
أمّا الباحث ديفيد موني، فيُشير إلى أنّ اللقاح الجديد سيساعد على تحسين معدلات إطالة عمر المرضى الذين يعانون من سرطان الدم النخاعي.
Researchers have developed an injectable, biomaterial-based vaccine that could lead to more effective treatment of a deadly blood cancer: https://t.co/PzYI0KMbmM @wyssinstitute @harvardstemcell @natBME @NIH @CancerResearch @NSF pic.twitter.com/wnMkcC601e
— Harvard SEAS (@hseas) January 15, 2020


















